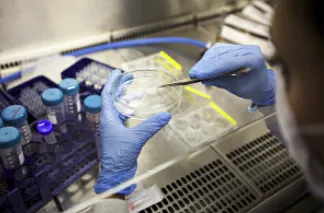

Undoubtedly, the jump from Lower Secondary to Upper Secondary O Level ‘E’ Math is a challenging one. O Level ‘E’ Math demands that students develop advanced critical thinking, reasoning, and metacognitive skills to solve real-world application problems. Finding O Level ‘E’ Math challenging and uninteresting, many students, including those who excelled in Lower Secondary Maths, end up losing their confidence in the subject. At Zenith, Singapore’s top secondary school tuition center, we strongly believe that this doesn’t have to be as such––the O Level ‘E’ Math journey can be immensely fulfilling, interesting, and enjoyable!
Here are five proven methods for going about your revision for the O Level ‘E’ Math papers, which will ensure you cover all bases before entering the exam hall.
Method #1: Practice, practice, practice
Perhaps more so for O Level ‘E’ Math than for any other subject, the adage “practice makes perfect” rings true. Math is a skill-based subject; this means that to do well, you need to develop a specific set of competencies, which have nothing to do with whether or not you have an “affinity” for the subject. Even if you do not think you are a “Math person”, you definitely have the capacity to do well for O Level ‘E’ Math. You just need to put in the time and effort to plow through practice questions for every single topic.
Since the O Level ‘E’ Math syllabus (Fig. 1) covers 10 topics under “Number and Algebra” and 8 topics under “Geometry and Measurement”, Zenith recommends that you do your revision regularly. Each of the 18 topics comprises between 2 to 16 key learning objectives, as such, it is almost impossible for you to cover all 18 topics if you only start revising a few weeks before the O Level ‘E’ Math papers. As a top secondary school math tuition center in Singapore, our carefully curated programme ensures that you develop a strong foundation for every topic before moving on to the next one.

*Do note that, due to the Covid-19 pandemic, G7 (vectors in two dimensions) will not be tested at the 2021 O Level ‘E’ Math examinations.
Method #2: Review your past assessments to identify the common mistakes you make
As Kirby Smart, a famous American football player-turned-coach once said, “It’s very important that we don’t make the same mistakes twice. That’s a big part of improvement.” Many O Level ‘E’ Math students often overlook the important post-assessment review process, especially as it can feel demoralising if you performed unsatisfactorily. However, if you want to do better for your subsequent assessments, you have to find out what you did wrong and rectify those errors. There is simply no effective way to improve if you have no idea what to focus on. Reviewing your past assessments might reveal that you tend to make errors when applying trigonometric formulae––you should then spend more time doing practice questions for trigonometry. Such an approach is especially relevant for O Level ‘E’ Math since similar questions are set in each year’s exam papers.
To make your revision process more effective and efficient, Zenith’s Math tuition programme also provides “cheat-sheets” that highlight commonly made mistakes. These sets of notes are distilled from hours of careful research, interviews with students, and analysis of markers’ reports––they are designed to help you preempt errors before you even make them! In addition, we also provide one-to-one assessment review sessions for all our students, where our educators dedicate time to help you devise an effective study plan going forward. This is important as the O Level ‘E’ Math journey is a two-year-long marathon; your success at the finishing line is dependent on consistent effort and good pacing. You neither want to be burnt out nor do you want to find yourself having to sprint for a whole 3 months leading up to the O Level ‘E’ Math paper.
Method #3: Focus on your weaker topics during your final rounds of revision
Once we have reviewed our assessments for what we did wrong, we should seek to improve on the topics that we’ve noticed weaknesses in. Everyone has different strengths and weaknesses. Some students excel at fractions, while others might find coordinate geometry a breeze. One common mistake students make is to allocate insufficient time to their weaker topics during the revision process which could be due to an overwhelming fear of doing poorly or a general sense of aversion towards that topic. Unfortunately, as long as a topic is included in the syllabus, questions about it will definitely appear on the exam paper.
At Zenith, we aim to make the O Level ‘E’ Math journey an enjoyable one for all our students. Rather than focusing on rote memorisation of question types and formulas, our educators break down complex concepts, facilitating in-depth understanding such that students are able to identify and apply the appropriate methods when it comes to solving O Level ‘E’ Math questions. At every juncture, we strive to add value to our students’ learning by drawing connections between Mathematical concepts and their daily applications.
Method #4: Complete the O Level ‘E’ Math ten-year-series (TYS)
The TYS is every candidate’s best friend when it comes to attempting practice papers. Before embarking on practice papers from other secondary schools in Singapore, it is advisable that you complete the TYS. The TYS is especially useful because the TYS reveals common questions that appear in the O Level ‘E’ Math papers. Identifying question trends from past year papers helps you to better understand the types of questions that may appear in your O Level ‘E’ Math paper. Preparing for these questions and doing extensive practice on them means that you will likely not be stumped when they appear during your exam. For instance, Fig 2 (Q6 of the 2019 O Level ‘E’ Math Paper 1) below shows an example of a common question for partial fractions. It demands that students perform cross-multiplication of the algebraic expressions in the denominator of each fraction, deriving a common denominator. From there on, they can get a single fraction, which they will have to reduce to and present in the simplest form.

Lastly, the TYS provides a plausible breakdown of marks allocated to each question/topic in the O Level ‘E’ Math papers. Students might find that more marks are allocated to some topics, such as “Algebraic Expressions and Formulae”, which continues to be an important topic should you enroll in a JC or a polytechnic programme where foundational Mathematical knowledge is required.
Method #5: Ask for help when you need it
As far as the cliche goes, asking for help is not a weakness. In fact, it can save you heaps of time––spending 2 hours trying to work out a really tricky question before giving up is not exactly productive. At Zenith, our team of dedicated educators is available round-the-clock for WhatsApp, Telegram, and Zoom online support. We also offer free one-to-one consultations, where our educators answer all your queries, review your past assessments with you and help you identify areas for further improvement. Find out more about the Zenith experience here.
Now that you know what to do before your O Level ‘E’ Math papers, it’s equally important that you know what to do during the exam itself. Method #6 to Method #9 will make sitting for your O Level ‘E’ Math papers a breeze.
Method #6: Complete all the questions you’re familiar with before returning to questions you got stuck on
As with every exam done under timed conditions, time is of the essence! At Zenith, we know that it is extremely frustrating when you get stuck on a question, especially if you just know that you have worked on a similar question before. However, you have to move on. Solving that one question for 4 marks at the expense of neglecting numerous questions you can perhaps get 12 marks for is just not worth it. Having to rush through questions you are familiar with increases the likelihood of you making careless mistakes. In a worst-case scenario, you simply will not have enough time to complete the entire O Level ‘E’ Math paper.

Breaking down the amount of time available for both O Level ‘E’ Math papers 1 (2 hours, as shown in Fig 3) and 2 (2 hours and 30 minutes, as shown in Fig 3), with time allocated for checking (which Zenith strongly recommends!), you should theoretically secure 1 mark for every 1.5 minutes, or preferably less. This means that you should not take more than 6 minutes for a 4-mark question. Of course, as in all exams, you will find some questions easier than others. For questions you are highly familiar with, you might need much less than 6 minutes to solve a 4-mark question. The leftover time that you do not use when attempting these easier questions is what you are using when you return to the questions you had some trouble with.
Method #7: Present your answers clearly
This is hardly rocket science, but disorganised, near illegible workings, irk markers. They have to arduously trawl through thousands of exam scripts during the marking period each year. Not surprisingly, workings that are scribbled messily make for an eyesore, which often impacts a candidate’s grades negatively. Writing neatly and legibly with minimal cancellations ensures that your marker can understand your workings with ease. This is precisely the reason why Zenith’s O Level Math tuition programme emphasizes the cultivation of positive exam-management skills. This enables students to minimise unnecessary errors, such as reading a question wrongly and having to reattempt it.
Method #8: Leave 5-10 minutes for checking
There’s no doubt about it––sitting for an exam is stressful. As a Secondary School tuition center, Zenith understands that studying for 8-9 subjects simultaneously is no easy feat. Often, students walking into exams are slightly on edge, which is something that is completely normal! Unfortunately, being in a state of frenzy means that we, as humans, are more likely to make mistakes, even if we do not usually make them. This is why setting time aside to check your paper is extremely important. For the O Level ‘E’ Math paper, look out for mistakes in presentation, calculation, and approximation. Students often lose marks for not rounding their final answers to the correct number of significant figures or decimal places, which can make the difference between an A1 or A2 grade when it comes to the unpredictable bell curve.

Ensuring that you are familiar with SEAB’s requirements for the O Level ‘E’ Math papers (Fig 4.) will reduce your likeliness of making such mistakes on the day of the examinations! Key points to remember include approximating your final answers to three-figure accuracy and maintaining a four-figure accuracy throughout your work. Exceptions only apply when stated in the question, or for angles, which should be given to one decimal place. Additionally, premature approximations can result in inaccurate answers. This will cause you to be double-penalized as marks are deducted separately for incorrect answers and mistakes in approximation.
Method #9: Breathe
Like tip #2, this tip might seem too straightforward. However, staying calm during an exam is more important than many people make it out to be! As Benjamin Spock once said, “trust yourself, you know more than you think you do”. Irrational anxiety during the O Level ‘E’ Math exam can cause you to become muddleheaded, making careless errors that you don’t usually make! While we have already established that it is undoubtedly nerve-wracking to be sitting for a national exam that can make a huge impact on subsequent pathways available to you, rest assured that your hard work will pay off! Walk into the exam hall confident that the preparation you’ve done is more than adequate! Being in a clear state of mind puts you in good stead to grapple with challenging questions, apply your knowledge and secure that distinction!
Acing the O Level ‘E’ Math Papers is definitely no easy feat, but with Zenith’s definitive guide on best practices to develop in preparation for it, we hope that you will feel more confident stepping into the exam hall!
Looking for study-buddies in a conducive learning environment? Want to be supported by a team of passionate educators who want the best for you? Keen to gain access to concise, effective, and easy-to-understand study notes? Click here to join the top O Level ‘E’ Math tuition programme in Singapore today! Otherwise, you can contact us for a free trial today or hear more about us from the testimonials here!